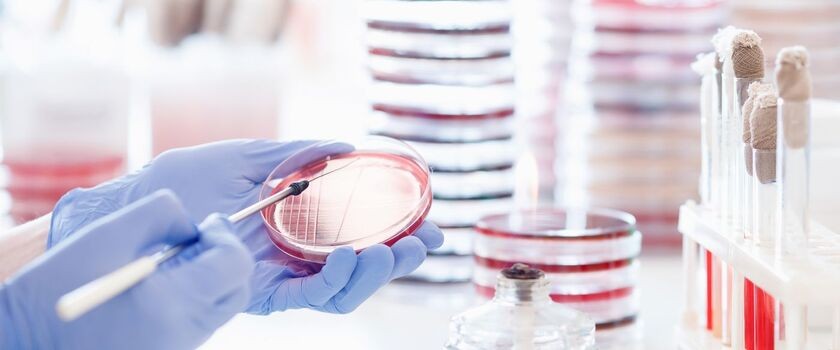

Czym są meningokoki? Objawy i profilaktyka inwazyjnej choroby meningokokowej
Bakterie z gatunku Neisseria meningitidis, potocznie nazywane meningokokami, są jednym z najbardziej podstępnych i gwałtownych zagrożeń dla ludzkiego zdrowia. W świecie mikrobiologii niewiele patogenów potrafi w tak błyskawicznym tempie doprowadzić organizm w pełni zdrowego człowieka do stanu bezpośredniego zagrożenia życia. Choć medycyna dysponuje potężnym arsenałem antybiotyków i nowoczesnych metod podtrzymywania funkcji życiowych, zakażenia meningokokowe wciąż budzą uzasadniony lęk zarówno wśród rodziców, jak i personelu medycznego. Niniejsze opracowanie ma na celu dogłębne wyjaśnienie natury tych drobnoustrojów, patomechanizmu wywoływanych przez nie schorzeń oraz przedstawienie najnowszych standardów w zakresie profilaktyki i terapii. Wiedza ta jest kluczem do szybkiej reakcji, która w przypadku inwazyjnej choroby meningokokowej (IChM) jest dosłownie na wagę złota.
- Czym są meningokoki?
- Co to jest choroba meningokokowa?
- Objawy inwazyjnej choroby meningokokowej
- Diagnostyka choroby meningokokowej
- Jak się leczy chorobę wywołaną przez meningokoki?
- Rokowania przy chorobie meningokokowej
- Powikłania po chorobie meningokokowej
- Profilaktyka zakażeń meningokokami i szczepienia
- Meningokoki i choroba meningokokowa – najczęściej zadawane pytania
Z tego artykułu dowiesz się:
- czym są meningokoki,
- jakie są typy meningokoków i gdzie występują,
- czym jest choroba meningokokowa,
- jakie są objawy choroby meningokokowej.
Dzięki temu artykułowi zrozumiesz, że meningokoki to przeciwnik, którego nie wolno lekceważyć. Wywoływana przez nie choroba meningokokowa jest jednym z najgwałtowniejszych stanów w medycynie, w którym granica między zdrowiem a walką o życie zaciera się w ciągu kilku godzin. Znajomość objawów, takich jak charakterystyczna wysypka nieblednąca pod uciskiem czy nagła wysoka gorączka, oraz świadomość istnienia „złotej godziny” mogą uratować życie. Najpotężniejszą bronią pozostaje jednak profilaktyka. Szczepienia ochronne przeciw typowi B oraz grupom A, C, W i Y znacząco zmniejszają ryzyko sepsy meningokokowej czy zapalenia opon. W obliczu tak nieprzewidywalnego zagrożenia wiedza i prewencja stają się fundamentem bezpieczeństwa naszych rodzin.
Czym są meningokoki?
Meningokoki to Gram-ujemne bakterie, które pod mikroskopem przyjmują charakterystyczny kształt ziarenek kawy ułożonych parami, dlatego w terminologii medycznej określa się je mianem dwoinek zapalenia opon mózgowo-rdzeniowych (Neisseria meningitidis). Ich naturalnym i jedynym rezerwuarem jest człowiek. Bakterie te wykazują silny tropizm do błon śluzowych górnych dróg oddechowych i zasiedlają jamę nosowo-gardłową.
Istotną cechą biologii tych drobnoustrojów jest ich niewielka odporność na warunki środowiska zewnętrznego. Są one niezwykle wrażliwe na zmiany temperatury, wysychanie oraz powszechnie stosowane środki dezynfekcyjne. Giną szybko po opuszczeniu organizmu gospodarza, co teoretycznie powinno ograniczać ich rozprzestrzenianie. Kiedy jednak przełamią bariery ochronne człowieka i przedostaną się do krwiobiegu, stają się bezlitosnym agresorem. Są otoczone wielocukrową otoczką, która chroni je przed mechanizmami obronnymi układu odpornościowego (fagocytozą) i umożliwia im szybkie namnażanie się i rozsiew w organizmie.
Typy meningokoków i ich występowanie
Różnorodność budowy antygenowej otoczki polisacharydowej meningokoków pozwoliła naukowcom na wyodrębnienie 12 grup serologicznych. Z punktu widzenia epidemiologii i zagrożenia dla zdrowia publicznego kluczowe znaczenie mają grupy oznaczone literami A, B, C, W oraz Y. To właśnie one odpowiadają za niemal wszystkie przypadki inwazyjnych zakażeń na świecie, choć ich dominacja jest silnie uzależniona od regionu geograficznego.
W Europie, w tym również w Polsce, krajobraz epidemiologiczny jest zdominowany przede wszystkim przez meningokoki typu B. Odpowiadają one za większość zachorowań, zwłaszcza w grupie niemowląt i małych dzieci. Na drugim miejscu plasują się bakterie z grupy C (19% zachorowań), które częściej atakują młodzież i młodych dorosłych. W ostatnich latach obserwuje się jednak niepokojący trend wzrostu zakażeń wywoływanych przez serogrupy W (7%) oraz Y (4%), co wymusza na epidemiologach ciągłą aktualizację strategii szczepień.
Co to jest choroba meningokokowa?
Inwazyjna choroba meningokokowa przyjmuje najczęściej dwie postacie, które często występują jednocześnie – ropne zapalenie opon mózgowo-rdzeniowych oraz posocznica meningokokowa (sepsa).
Choroba rzadziej przybiera inne formy, np. zapalenie ucha, płuc, gardła, nagłośni czy stawów. Statystyki medyczne wskazują, że zapalenie opon występuje częściej, jednak to sepsa obarczona jest znacznie wyższym ryzykiem zgonu. W przebiegu IChM dochodzi do gwałtownej reakcji zapalnej całego organizmu, co prowadzi do uszkodzenia śródbłonka naczyń krwionośnych, zaburzeń krzepnięcia i w konsekwencji do niewydolności wielonarządowej. Należy pamiętać, że choroba ta rozwija się w sposób piorunujący – od pełni zdrowia do stanu krytycznego mogą upłynąć zaledwie 24 godziny.
Objawy inwazyjnej choroby meningokokowej
Zakażenie meningokokami – pierwsze objawy u dzieci i dorosłych
Na początku dominują objawy grypopodobne:
- ogólne rozbicie, bóle mięśniowo-stawowe, podwyższona temperatura oraz dreszcze;
- często pojawiają się nudności, wymioty oraz brak apetytu;
- u niemowląt objawy mogą być jeszcze mniej charakterystyczne – drażliwość, płaczliwość, senność, niechęć do jedzenia czy pulsowanie ciemiączka.
Objawy zapalenia opon mózgowych w chorobie meningokokowej
W miarę postępu choroby, zazwyczaj w ciągu kilku do kilkunastu godzin, stan chorego drastycznie się pogarsza. Pojawiają się symptomy typowe dla zapalenia opon mózgowo-rdzeniowych:
- silny, narastający ból głowy, którego nie łagodzą standardowe leki przeciwbólowe;
- sztywność karku (uniemożliwiająca przygięcie brody do klatki piersiowej);
- światłowstręt;
- nadwrażliwość na dźwięki;
- w skrajnych przypadkach dochodzi do zaburzeń świadomości, drgawek, a nawet śpiączki.
Objawy posocznicy meningokokowej
Jeśli dominującą formą jest posocznica meningokokowa (sepsa), obraz kliniczny obejmuje dodatkowo objawy wstrząsu:
- bladość lub szarość powłok skórnych;
- zimne dłonie i stopy;
- przyspieszony oddech oraz tętno;
- spadek ciśnienia tętniczego krwi.
Jak rozpoznać wysypkę meningokokową?
Jednym z najbardziej charakterystycznych i alarmujących objawów zakażenia jest wysypka meningokokowa. Nie jest to jednak typowa wysypka alergiczna czy wirusowa, ale uszkodzenie naczyń krwionośnych przez toksyny bakteryjne. Początkowo zmiany mogą przypominać drobne ukłucia szpilką – są to wybroczyny (petechiae) o barwie czerwonej lub fioletowej, które mogą pojawić się w dowolnym miejscu na ciele, choć często najpierw lokalizują się na tułowiu i kończynach dolnych. Z czasem wybroczyny mogą zlewać się w większe plamy i tworzyć rozległe wylewy podskórne przypominające siniaki (plamica).
Kluczowym narzędziem różnicowania jest tzw. test szklanki. Polega on na przyciśnięciu boku przezroczystej szklanki do zmian na skórze.
Jeśli zaobserwujemy taki objaw, należy bezzwłocznie wezwać pogotowie ratunkowe, gdyż świadczy to o procesie chorobowym i postępującej sepsie. Wysypka meningokokowa jest objawem charakterystycznym IChM, jednak nie występuje zawsze.

Diagnostyka choroby meningokokowej
Podstawą jest pobranie krwi na posiew oraz – jeśli nie ma przeciwwskazań takich jak obrzęk mózgu – wykonanie punkcji lędźwiowej w celu pobrania płynu mózgowo-rdzeniowego. Płyn ten poddawany jest ocenie ogólnej (poziom białka, glukozy, cytoza) oraz posiewowi bakteriologicznemu.
Obecnie coraz częściej wykorzystuje się nowoczesne metody biologii molekularnej takie jak reakcja łańcuchowa polimerazy (PCR). Pozwalają one na wykrycie materiału genetycznego Neisseria meningitidis w ciągu kilku godzin, co znacznie przyspiesza celowaną terapię. Dodatkowo wykonuje się badania parametrów stanu zapalnego (CRP, prokalcytonina) oraz morfologię krwi, która w przypadku sepsy wykazuje znaczne odchylenia od normy.
|
|
|
Jak się leczy chorobę wywołaną przez meningokoki?
Fundamentem terapii jest dożylne podawanie silnych antybiotyków. W pierwszej fazie, gdy typ bakterii nie jest jeszcze znany, stosuje się antybiotyki o szerokim spektrum działania (najczęściej cefalosporyny III generacji, np. ceftriakson lub cefotaksym). Po uzyskaniu antybiogramu terapia może zostać zmodyfikowana na bardziej celowaną, np. z zastosowaniem penicyliny krystalicznej, jeśli szczep jest na nią wrażliwy.
Równolegle z antybiotykoterapią prowadzone jest intensywne leczenie objawowe i podtrzymujące:
- pacjent z sepsą wymaga agresywnej płynoterapii w celu utrzymania ciśnienia krwi i perfuzji narządów;
- często konieczne jest podawanie leków wazopresyjnych (obkurczających naczynia);
- w przypadku niewydolności oddechowej pacjent jest intubowany i podłączany do respiratora;
- w przypadku nasilonego obrzęku mózgu stosuje się leki przeciwobrzękowe i glikokortykosteroidy (np. deksametazon, stosowany głównie przy zapaleniu opon mózgowych, ale zazwyczaj nie przy sepsie), które mogą zmniejszyć ryzyko trwałych powikłań neurologicznych, szczególnie utraty słuchu.
Walka toczy się o zahamowanie kaskady zapalnej i zapobieganie niewydolności nerek, wątroby oraz serca.
Rokowania przy chorobie meningokokowej
Mimo postępu medycyny rokowania w IChM pozostają poważne. Śmiertelność w przypadku choroby meningokokowej wynosi średnio około 10%, jednak w przypadku wstrząsu septycznego może sięgać nawet 4–50%, zwłaszcza u osób starszych lub z osłabioną odpornością. Ryzyko zgonu zależy także od stopnia ciężkości choroby i współistniejących czynników ryzyka.
Kluczowym czynnikiem wpływającym na przeżywalność jest czas, który upłynął od wystąpienia pierwszych objawów do wdrożenia antybiotykoterapii. Tak zwana „złota godzina” ma tu zastosowanie dosłowne – każda minuta zwłoki zmniejsza szanse pacjenta na pełny powrót do zdrowia.
Powikłania po chorobie meningokokowej
Dla pacjentów, którym uda się przetrwać ostrą fazę choroby, walka o zdrowie często się nie kończy. Powikłania po przebyciu IChM dotykają nawet co piątego ozdrowieńca, mogą mieć charakter trwały i wpływać na jakość życia przez długie lata. Do najczęstszych następstw neurologicznych należą: głęboki niedosłuch lub całkowita głuchota (wynik uszkodzenia struktur narządu słuchu), padaczka, niedowłady kończyn, a także zaburzenia koncentracji i trudności w uczeniu się u dzieci.
Posocznica meningokokowa, prowadząca do zaburzeń krzepnięcia i zatorów w drobnych naczyniach, może skutkować martwicą tkanek. W drastycznych przypadkach konieczne są amputacje palców, fragmentów kończyn, a nawet całych rąk czy nóg. Ponadto rozległe uszkodzenia skóry wymagają często wieloetapowego leczenia chirurgicznego i przeszczepów skóry, które pozostawiają rozległe, szpecące blizny. Nie można również pominąć aspektu psychologicznego – przebycie tak ciężkiej choroby i pobyt na OIT jest dla pacjenta i jego rodziny ogromną traumą, która może prowadzić do zespołu stresu pourazowego (PTSD).
Profilaktyka zakażeń meningokokami i szczepienia
Najskuteczniejszą metodą walki z meningokokami są szczepienia ochronne. Nie istnieje jedna uniwersalna szczepionka przeciwko wszystkim typom tych bakterii, dlatego strategia profilaktyczna opiera się na stosowaniu kilku preparatów. Dostępne są szczepionki skoniugowane przeciw meningokokom grupy C, szczepionki skoniugowane wieloważne (przeciwko grupom A, C, W, Y) oraz relatywnie nowe osiągnięcie medycyny – szczepionki białkowe przeciwko meningokokom grupy B.
Wielu rodziców zastanawia się, kiedy szczepić na meningokoki. Zgodnie z Kalendarzem Szczepień Ochronnych optymalnym czasem na rozpoczęcie immunizacji jest okres niemowlęcy, najlepiej już od 2. miesiąca życia. Wynika to z faktu, że szczyt zachorowań przypada właśnie na pierwszy rok życia dziecka (33% wszystkich zachorowań to dzieci w 1. roku życia), kiedy jego układ odpornościowy jest jeszcze niedojrzały, a przeciwciała odmatczyne zanikają.
Drugą grupą, której zaleca się szczepienia, jest młodzież w wieku 14–19 lat ze względu na styl życia sprzyjający transmisji bakterii (przebywanie w grupach, imprezy, intymne kontakty).
Oprócz szczepień istotna jest także profilaktyka nieswoista:
- unikanie zatłoczonych miejsc w okresach zwiększonej zachorowalności;
- dbanie o higienę rąk;
- niekorzystanie ze wspólnych naczyń czy sztućców.
W przypadku bliskiego kontaktu z osobą chorą na IChM (np. domownicy, dzieci w przedszkolu) stosuje się chemioprofilaktykę. Polega ona na jednorazowym podaniu antybiotyku (np. ciprofloksacyny, ryfampicyny lub ceftriaksonu) wszystkim osobom z otoczenia chorego, aby zapobiec rozwojowi choroby.
Meningokoki i choroba meningokokowa – najczęściej zadawane pytania
Gdzie można się zarazić meningokokami?
Meningokoki przenoszą się wyłącznie drogą kropelkową (kaszel, kichanie), przez bezpośredni (np. pocałunek) lub pośredni (dzielenie się jedzeniem czy używanie tych samych sztućców) kontakt z wydzieliną z dróg oddechowych nosiciela lub chorego. Do zakażenia nie wystarczy przebywanie w tym samym pokoju. Ryzyko wzrasta w dużych skupiskach ludzi, stąd częste ogniska epidemiczne w żłobkach, przedszkolach, akademikach, internatach czy koszarach wojskowych. Bakteria jest wrażliwa na środowisko zewnętrzne i ginie dość szybko, więc raczej nie złapiemy jej z klamki czy deski toaletowej, pod warunkiem że powierzchnie te nie miały bezpośredniego kontaktu ze świeżą wydzieliną.
Co jest gorsze, pneumokoki czy meningokoki?
Zarówno pneumokoki (Streptococcus pneumoniae), jak i meningokoki mogą wywoływać zapalenie opon mózgowo-rdzeniowych i sepsę. Różnica polega na dynamice i statystyce. Zakażenia pneumokokowe są znacznie częstsze, szczególnie u małych dzieci i osób starszych, i odpowiadają za większą ogólną liczbę zgonów oraz przypadków zapalenia płuc czy ucha. Meningokoki są jednak postrzegane jako groźniejsze ze względu na nieprzewidywalność i błyskawiczny przebieg. Choroba meningokokowa częściej zabija w ciągu 24 godzin w pełni zdrowego człowieka i częściej pozostawia po sobie dramatyczne ślady w postaci amputacji czy rozległych blizn po wybroczynach.
Jaka jest różnica między meningokokami B i C?
Główna różnica leży w budowie otoczki bakteryjnej, co przekłada się na epidemiologię i dostępność szczepionek. Typ B jest obecnie dominującym patogenem w Polsce i większości krajów Europy – odpowiada za około 60–70% przypadków IChM u dzieci. Typ C był dawniej bardzo powszechny, ale dzięki masowym programom szczepień w wielu krajach jego udział w zachorowaniach spadł. Opracowanie preparatu przeciwko typowi B było znacznie trudniejsze (ze względu na podobieństwo antygenów bakterii do tkanek ludzkich), dlatego szczepionka ta pojawiła się na rynku znacznie później niż szczepienie przeciwko typowi C.
Czy meningokoki są groźne dla dorosłych?
Tak, choć ryzyko zachorowania jest statystycznie niższe niż u niemowląt. Dorośli są zagrożeni, zwłaszcza jeśli mają osłabioną odporność, np. z powodu braku śledziony, zakażenia HIV czy chorób przewlekłych. Specyficzną grupą ryzyka są seniorzy, u których układ odpornościowy prowadzi do osłabienia odpowiedzi immunonologicznej i zwiększonej podatności na infekcje. Ponadto dorośli często podróżują do rejonów endemicznego występowania meningokoków, co naraża ich na kontakt z serogrupami rzadkimi w ich kraju ojczystym. Sezonowe zachorowania zdarzają się również wśród zdrowych młodych dorosłych, np. studentów mieszkających w akademikach.
Czym jest nosicielstwo meningokoków?
Nosicielstwo to stan, w którym bakterie Neisseria meningitidis bytują w jamie nosowo-gardłowej człowieka, ale nie wywołują żadnych objawów chorobowych. Szacuje się, że około 10–25% populacji (a w okresach epidemii nawet więcej) może być nosicielami. Najwyższy odsetek nosicieli obserwuje się wśród młodzieży i młodych dorosłych (w zależności od grupy wiekowej – u dorosłych jest to bliżej 10%, u nastolatków bliżej górnej granicy tego zakresu). Choć sam nosiciel nie choruje, może nieświadomie przekazać bakterie osobom wrażliwym, np. swojemu dziecku lub rodzeństwu, u których rozwinie się pełnoobjawowa, inwazyjna choroba. To właśnie zjawisko nosicielstwa sprawia, że całkowita eliminacja meningokoków ze środowiska jest tak trudna.


 Strefa okazji
Strefa okazji
 Nowości
Nowości
 Krótkie daty
Krótkie daty





























